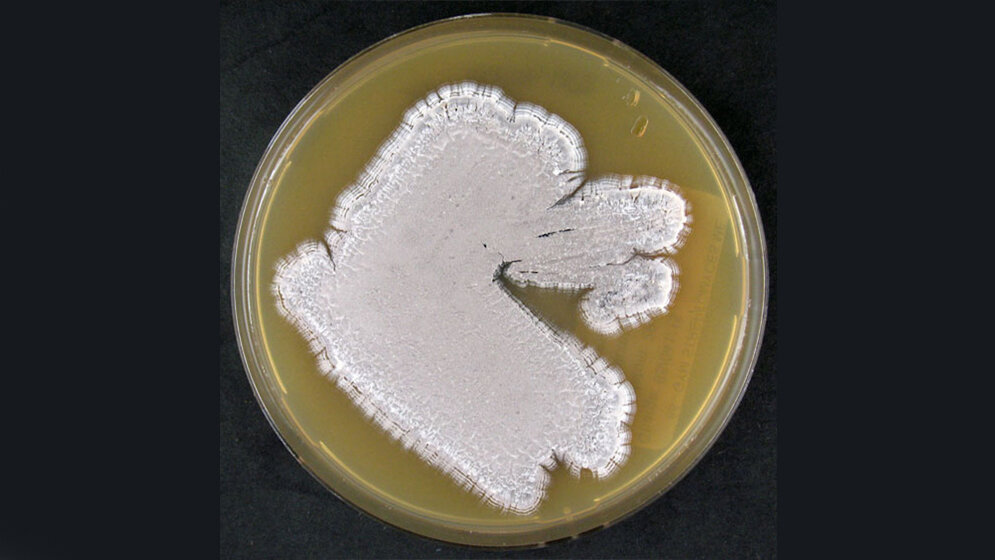
Agarplatte_bewachsen_mit_S_pristinaespiralis_DSM_40338_DSMZ.jpg Agarplatte

Forscher/-innen rund um Professorin Dr. Yvonne Mast vom Leibniz-Institut DSMZ-Deutsche Sammlung von Mikroorganismen und Zellkulturen GmbH im niedersächsischen Braunschweig haben erstmalig einen Teil der Autoregulation in der Biosynthese des Antibiotikums Pristinamycin entschlüsselt. Als Notfallmedikament setzen Mediziner Pristinamycin gegen Antibiotika-resistente pathogene Bakterien ein. Ihre Ergebnisse publizierten die Forschenden gerade erst.
Regulation der Antibiotikaproduktion in Streptomyceten
Streptomyces pristinaespiralis gehört zu den Streptomyceten, einer Bakteriengruppe, die eine Vielzahl an Stoffwechselprodukten, darunter verschiedene Antibiotika, herstellen. Die Antibiotikaproduktion in Streptomyceten unterliegt komplexen regulatorischen Netzwerken, die auf äußere Einflüsse wie physiologische Parameter flexibel reagieren. Wichtige Signalmoleküle sind dabei die sogenannten gamma-Butyrolactone (GBL), die in den meisten Streptomyceten-Arten vorkommen und dort als eine Art mikrobielles Hormon im Rahmen des Quorum sensing die Antibiotika-Produktion initiieren. Im Pristinamycin-Produzentenstamm S. pristinaespiralis ist weder die Struktur des Signalmoleküls noch die dafür kodierende Gensequenz bekannt. In der publizierten Studie konnten die Forscher/-innen rund um Prof. Yvonne Mast zum ersten Mal nachweisen, dass insgesamt drei verschiedene Regulatoren (SpbR, PapR3 und PapR5) als GBL-Rezeptoren agieren und durch Bindung des GBL Einfluss auf die Pristinamycin-Produktion nehmen.
Besseres Verständnis der Regulation der Biosynthese
„Noch ist unklar, ob alle drei Rezeptoren das gleiche Signalmolekül binden. Bioinformatische Simulationen lassen vermuten, dass der Rezeptor PapR3 ein strukturell anderes Molekül bindet als die anderen beiden Rezeptoren“, fasst die Mikrobiologin Yvonne Mast das Studienergebnis zusammen. In weiteren Experimenten konnten die Forschenden erstmals ein Gen (snbU) identifizieren, welches an der Biosynthese des Pristinamycin-GBL-Signalmoleküls beteiligt ist. Zudem konnten die Forscher/-innen durch externe Zugabe eines synthetischen GBLs die Pristinamycin-Produktion steigern. „Unsere Daten tragen zu einem besseren Verständnis der Regulation der Biosynthese von Antibiotika bei. Das Pristinamycin-Regulationssystem ist mittlerweile relativ gut untersucht und dient als Modellsystem um Antibiotika-Produktionsprozesse in Streptomyceten generell besser zu verstehen. Ein besseres Verständnis, welche Signalmoleküle in die Regulation der Antibiotikaproduktion involviert sind, liefert Möglichkeiten, um gezielt Antibiotika-Produktionen zu optimieren aber auch um sogenannte stille Gencluster zu aktivieren um neue Antibiotika zu finden“, blickt Professorin Mast in die Zukunft.
Yvonne Mast leitet seit 2019 die Abteilung Bioressourcen für Bioökonomie und Gesundheitsforschung am Leibniz-Institut DSMZ in Braunschweig. Der Forschungsschwerpunkt der Abteilung liegt in der Untersuchung des Potenzials von biologischem Material für die Anwendung in der Humanmedizin und Biotechnologie.
Handel F, Kulik A and Mast Y (2020): Investigation of the Autoregulator-Receptor System in the Pristinamycin Producer Streptomyces pristinaespiralis. Front. Microbiol. 11: 580990, DOI: 10.3389/fmicb.2020.580990.
Quelle: idw/Leibniz-Institut DSMZ-Deutsche Sammlung von Mikroorganismen und Zellkulturen GmbH
Artikel teilen